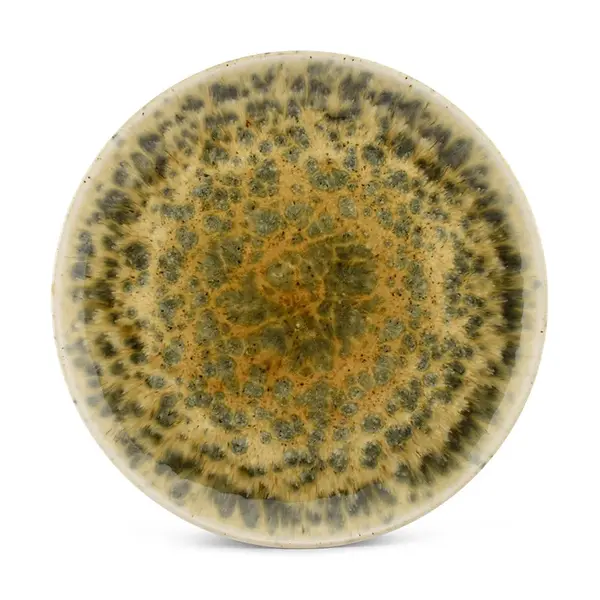

Talíř BonBistro Resto hnědá barva
Dostupné v dalších obchodech
Popis produktu
Talíř z kolekce BonBistro. Model vyroben z porcelánu.
Specifikace
- Stav: new
- Typ produktu:Talíře
- GTIN/EAN: 05410595752102
- Materiál: Porcelán
- Barva: hnědá
- Prodejce/Program: Answear.cz




